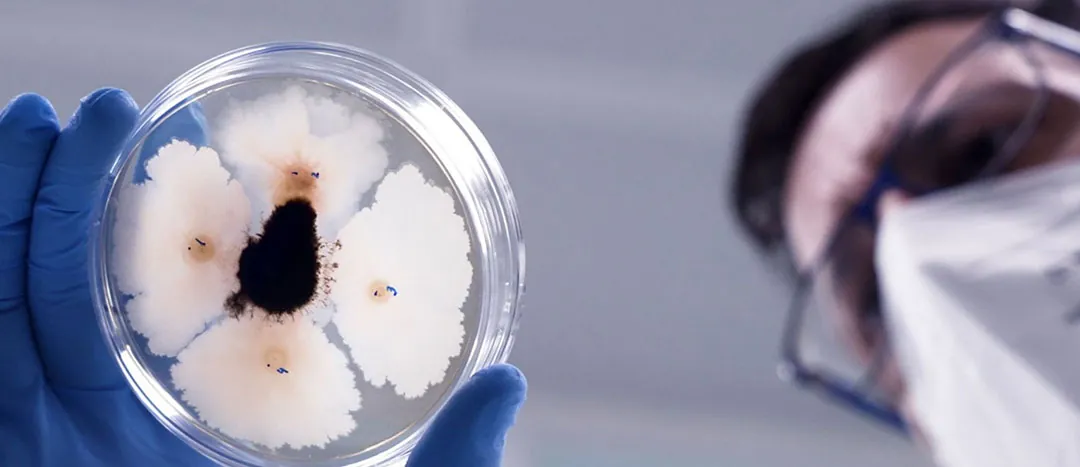
Placa de cultivo de microorganismos para tecnología básica Placa de cultivo de microorganismos para tecnología básica

La agricultura de vanguardia es un eslabón estratégico en la cadena de suministro alimentario. Estos cultivos no solo tienen el reto de abastecer a los mercados con frutas y hortalizas de máxima frescura, sino que deben hacerlo bajo estándares de sostenibilidad muy rigurosos. La reducción de la huella de carbono y la limitación de insumos de síntesis química han dejado de ser opciones para convertirse en requisitos de mercado.
Para entender cómo la ciencia de vanguardia apoya este modelo de agricultura profesional, mantenemos un coloquio técnico con Antonio Bernal Soro, Chief R&D Officer de Agronova biotech. Esta plataforma global de innovación integra a firmas de la relevancia de Probelte, empresa asociada a AEFA, lo que asegura que la transferencia tecnológica que abordamos hoy tenga una aplicación directa y profesional en el campo.

La investigación básica como cimiento de la rentabilidad agrícola.
En el equipo de redacción de Elhuertourbano.net sabemos que el agricultor no puede permitirse errores en la planificación de sus cultivos. La presión por obtener rendimientos constantes en superficies a menudo limitadas exige insumos de una fiabilidad absoluta. Antonio Bernal rompe con el mito de que la investigación básica es algo teórico y alejado de la realidad económica.
Según Bernal, la investigación básica es la que permite construir una «biblioteca» de activos biológicos. Para un cultivo hortícola que debe estar en el mercado en el menor tiempo posible tras su recolección, disponer de bioestimulantes cuya base científica ha sido testada exhaustivamente garantiza una respuesta predecible.
Para las empresas formuladoras de productos bioestimulantes agrícolas y de biocontrol, «disponer de una base sólida de investigación evita comenzar de cero y optimizar el uso de recursos», señala Bernal. Esta eficiencia es muy importante para mantener la competitividad en un sector que busca la excelencia productiva con el mínimo impacto medioambiental.
El «Strain Bank» de Agronova pone la diversidad microbiana al servicio del agricultor profesional.
Uno de los pilares de nuestra conversación se centra en la gestión de los microorganismos. El Agronova Strain Bank (cepario) es descrito por Bernal no como un repositorio, sino como una herramienta estratégica dinámica. En la agricultura profesional, donde el suelo suele estar sometido a una rotación intensa, la reintroducción de vida microbiana caracterizada es fundamental.
Este banco de cepas se nutre de una bioprospección constante en diversos ecosistemas. Para ello, el equipo de Bernal realiza la identificación molecular en las propias instalaciones de la empresa mediante técnicas de secuenciación de lectura larga.
¿Qué significa esto para el técnico agrícola? Significa trazabilidad. Significa saber que el consorcio microbiano que está aplicando para mejorar el sistema radicular de un determinado cultivo ha sido identificado hasta el nivel genómico, garantizando su estabilidad y su funcionalidad en condiciones reales de campo.
Caracterización funcional para maximizar la eficiencia de los bioestimulantes.
El concepto de bioestimulante es amplio, pero en la agricultura profesional, la especificidad es la que marca la rentabilidad. Bernal explica cómo someten a los microorganismos a una caracterización integral. No basta con que una cepa sea «buena»; el profesional necesita saber exactamente qué hace.
En los laboratorios de Agronova biotech se evalúan de forma sistemática capacidades clave como son la movilización de nutrientes, porque a menudo, terrenos saturados por años de cultivo, su capacidad de solubilizar fósforo o fijar nitrógeno atmosférico es delicada para reducir la huella de carbono vinculada a los fertilizantes agrícolas de síntesis.
También la producción de metabolitos secundarios. Aquellos que activan las defensas naturales de la planta o mejoran su respuesta al estrés abiótico. Y la interacción con el microbioma autóctono y para ello se estudian cómo estos microorganismos se integran en el ecosistema del suelo existente, midiendo la actividad enzimática.
Esto asegura que la aplicación del producto no sea un evento aislado, sino una mejora sistémica del patrimonio biológico de la explotación.
La bioprospección como proceso de validación riguroso de un microorganismo.
El camino que recorre un microorganismo desde que es hallado en la naturaleza hasta que llega a formar parte de un producto comercial en la estantería de un almacén de suministros es largo y exigente. En este contexto, el proceso de bioprospección comienza con la recogida de muestras en suelos y aguas con perfiles físico-químicos diversos.
Posteriormente, en los laboratorios centrales, el equipo de fitopatología evalúa el potencial agronómico real. Antonio Bernal pone especial énfasis en el perfil de seguridad. Para ello, mediante la secuenciación completa del genoma, se anticipan a cualquier requisito regulatorio, asegurando que el producto sea inocuo para el medioambiente y para el consumidor final.
La genómica y cumplimiento del Reglamento (UE) 2019/1009.
La agricultura debe ser ejemplar en el cumplimiento de la legislación y en este sentido, el Reglamento (UE) 2019/1009 establece un marco estricto para los productos fertilizantes y bioestimulantes europeos. Bernal destaca que las técnicas de secuenciación y predicción de genes son hoy «absolutamente clave» para la correcta asignación taxonómica y la anotación funcional.
Esta tecnología permite predecir funcionalidades desde fases muy tempranas y con ella se reduce el tiempo de llegada al mercado de soluciones innovadoras y garantiza que lo que indica la etiqueta está respaldado por una realidad genética comprobada. Es la ciencia aplicada para evitar el «ruido» en el mercado de insumos y ofrecer al agricultor herramientas que realmente aporten valor a su cuenta de resultados.

El factor humano en la transferencia tecnológica de bioestimulantes y biocontrol.
Agronova Biotech cuenta con más de 30 profesionales de alta especialización en I+D, repartidos en laboratorios de España, Portugal y Estados Unidos. Esta estructura permite a Antonio Bernal combinar una visión global con una aplicación local. Bajo este prisma, el equipo multidisciplinar formado por microbiólogos, biotecnólogos y agrónomos, trabaja de forma integrada.
En Elhuertourbano.net valoramos especialmente esta conexión. El investigador que diseña el producto en el laboratorio debe entender los desafíos del agricultor: la necesidad de precocidad, la calidad organoléptica y la sanidad vegetal sin residuos. Solo a través de esta coordinación se logra una transferencia tecnológica eficaz que resuelva problemas reales.
La resiliencia y futuro de la agricultura.
El cambio climático y las restricciones en el uso de materias activas tradicionales plantean un escenario incierto. Sin embargo, el modelo que nos describe Antonio Bernal ofrece una vía de optimismo basada en el rigor. La capacidad de seleccionar los mejores candidatos microbianos desde fases muy tempranas permite que la agricultura gane en resiliencia.
«Este enfoque permite realizar un uso mucho más eficiente de los recursos», afirma Bernal. Al reducir los riesgos en la cadena de desarrollo, las empresas como Agronova Biotech y Probelte pueden poner en el mercado soluciones más robustas y rápidas. En este marco, para el profesional de la agricultura, esto se traduce en disponer de un catálogo biotecnológico de última generación para seguir produciendo alimentos sanos, seguros y sostenibles.
La transferencia tecnológica a partir de la investigación básica es, en definitiva, el motor que permite que la agricultura de baja huella de carbono pase de ser una aspiración a una realidad rentable y científicamente avalada.







